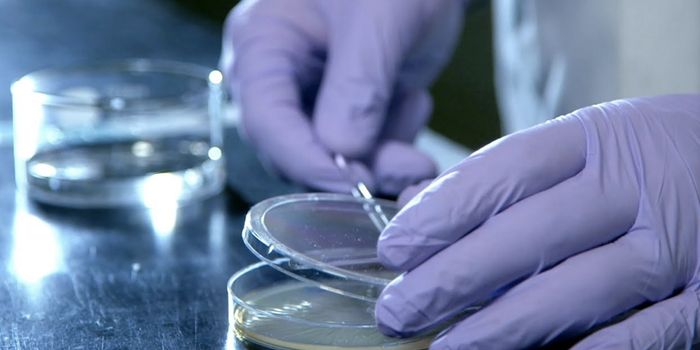
Learning how Bacterial Chemicals Impact Human Health

Colon Cancer
Colon Cancer: is a type of cancer that begins in the large intestine (colon). Colon cancer typically affects older adults, though it can happen at any age. It usually begins as small, noncancerous (benign) clumps of cells called polyps that form on the inside of the colon. Over time some of these polyps can become colon cancers.
-
JUN 22, 2019CancerHave you flossed recently? New research links poor gum health to liver cancer, adding the disease to the long list of ot ...Written By: Kathryn DeMuth SullivanJUN 12, 2019MicrobiologyThis new type of pathogen is thought to be something in between a bacterium and a virus.Written By: Carmen LeitchMAY 10, 2019CancerYou may want to reschedule that late afternoon doctor’s appointment. A new study published today in JAMA Network O ...Written By: Kathryn DeMuth SullivanMAY 05, 2019MicrobiologyHelicobacter pylori doesn't only withstand the harsh stomach environment, it can thrive there, sometimes causing ulcers ...Written By: Carmen LeitchMAY 05, 2019CancerColorectal cancer is the third most common cancer in the U.S. among both men and women and the third leading cause of ca ...Written By: Kathryn DeMuth SullivanAPR 21, 2019MicrobiologyAntibiotic-resistant infections cause the deaths of about 23,000 Americans every year. By 2050, they're projected to kil ...Written By: Carmen LeitchAPR 17, 2019MicrobiologyScientists are using genetic tools to engineer bacteria in many ways. These new microbes are able to mimic or sense dise ...Written By: Carmen LeitchAPR 09, 2019MicrobiologyResearchers want to identify and characterize the microbes hosted by the human body to understanding how they impact our ...Written By: Carmen LeitchAPR 02, 2019CancerThe primary goals of metastatic breast cancer treatment are to ensure that the patient has the longest survival pos ...Written By: Aleishia Harris-ArnoldFEB 26, 2019CancerA recent review in the Annals of Internal Medicine compared 30 studies on at-home colon cancer tests called FITs (f ...Written By: Amy LoriauxFEB 21, 2019Genetics & GenomicsWhile cancer rates are dropping in general, colorectal cancer is becoming more common in people under the age of 55.Written By: Carmen LeitchFEB 02, 2019CardiologyPalliative care is end-of-life care focused on making the very ill more comfortable in their final days. This type of ca ...Written By: Abbie ArceJAN 30, 2019ImmunologyA new immune signaling molecule now provides the basis for potential new approaches in sepsis therapy.Written By: Nicholas BreehlJAN 23, 2019Health & MedicineToday, women face a variety of challenging health issues, both physical and psychological which, in the past, have not r ...Written By: Dena ArutaJAN 17, 2019MicrobiologyThe community of microbes in our gut is critical to our health. If it's out of balance, researchers are investigating wh ...Written By: Carmen LeitchJAN 12, 2019CardiologyWe’ve all heard that getting more fiber is good for a healthier gut. Experts in nutrition and the latest national ...Written By: Abbie ArceDEC 18, 2018VideosThe video above features the latest Koch Institute Image Award winner.Written By: Carmen LeitchNOV 21, 2018Drug Discovery & DevelopmentFrom a failed pain drug, a protein called ‘BH4’, was recently discovered to have surprising implications in ...Written By: Nouran AminNOV 14, 2018ImmunologyUsing the power of the immune system to eliminate cancerous cells has long the been the goal of immuno-oncology. Immune ...Written By: Aleishia Harris-ArnoldOCT 14, 2018ImmunologyScientists reveal a pathway involved in cancer cell ability to act as stem cellsWritten By: Nicholas BreehlOCT 02, 2018VideosWe play host to a huge number of microbes, and all the chemicals that they produce.Written By: Carmen LeitchSEP 18, 2018MicrobiologyWe coexist with microorganisms, and many of them play an important role in our health.Written By: Carmen LeitchSEP 15, 2018Clinical & Molecular DXAnoikis have always been intimately entwined with cancer, henceforth the quest to seek how they came to be as such.Written By: Sharvin ManickamSEP 01, 2018CancerWe have always been told to eat more vegetables as they are rich in many nutrients and vitamins as well as the ability t ...Written By: Heba El-wassef
JUN 22, 2019
Cancer
Have you flossed recently? New research links poor gum health to liver cancer, adding the disease to the long list of ot
...
Written By:
Kathryn DeMuth Sullivan
JUN 12, 2019
Microbiology
This new type of pathogen is thought to be something in between a bacterium and a virus.
Written By:
Carmen Leitch
MAY 10, 2019
Cancer
You may want to reschedule that late afternoon doctor’s appointment. A new study published today in JAMA Network O
...
Written By:
Kathryn DeMuth Sullivan
MAY 05, 2019
Microbiology
Helicobacter pylori doesn't only withstand the harsh stomach environment, it can thrive there, sometimes causing ulcers
...
Written By:
Carmen Leitch
MAY 05, 2019
Cancer
Colorectal cancer is the third most common cancer in the U.S. among both men and women and the third leading cause of ca
...
Written By:
Kathryn DeMuth Sullivan
APR 21, 2019
Microbiology
Antibiotic-resistant infections cause the deaths of about 23,000 Americans every year. By 2050, they're projected to kil
...
Written By:
Carmen Leitch
APR 17, 2019
Microbiology
Scientists are using genetic tools to engineer bacteria in many ways. These new microbes are able to mimic or sense dise
...
Written By:
Carmen Leitch
APR 09, 2019
Microbiology
Researchers want to identify and characterize the microbes hosted by the human body to understanding how they impact our
...
Written By:
Carmen Leitch
APR 02, 2019
Cancer
The primary goals of metastatic breast cancer treatment are to ensure that the patient has the longest survival pos
...
Written By:
Aleishia Harris-Arnold
FEB 26, 2019
Cancer
A recent review in the Annals of Internal Medicine compared 30 studies on at-home colon cancer tests called FITs (f
...
Written By:
Amy Loriaux
FEB 21, 2019
Genetics & Genomics
While cancer rates are dropping in general, colorectal cancer is becoming more common in people under the age of 55.
Written By:
Carmen Leitch
FEB 02, 2019
Cardiology
Palliative care is end-of-life care focused on making the very ill more comfortable in their final days. This type of ca
...
Written By:
Abbie Arce
JAN 30, 2019
Immunology
A new immune signaling molecule now provides the basis for potential new approaches in sepsis therapy.
Written By:
Nicholas Breehl
JAN 23, 2019
Health & Medicine
Today, women face a variety of challenging health issues, both physical and psychological which, in the past, have not r
...
Written By:
Dena Aruta
JAN 17, 2019
Microbiology
The community of microbes in our gut is critical to our health. If it's out of balance, researchers are investigating wh
...
Written By:
Carmen Leitch
JAN 12, 2019
Cardiology
We’ve all heard that getting more fiber is good for a healthier gut. Experts in nutrition and the latest national
...
Written By:
Abbie Arce
DEC 18, 2018
Videos
The video above features the latest Koch Institute Image Award winner.
Written By:
Carmen Leitch
NOV 21, 2018
Drug Discovery & Development
From a failed pain drug, a protein called ‘BH4’, was recently discovered to have surprising implications in
...
Written By:
Nouran Amin
NOV 14, 2018
Immunology
Using the power of the immune system to eliminate cancerous cells has long the been the goal of immuno-oncology. Immune
...
Written By:
Aleishia Harris-Arnold
OCT 14, 2018
Immunology
Scientists reveal a pathway involved in cancer cell ability to act as stem cells
Written By:
Nicholas Breehl
OCT 02, 2018
Videos
We play host to a huge number of microbes, and all the chemicals that they produce.
Written By:
Carmen Leitch
SEP 18, 2018
Microbiology
We coexist with microorganisms, and many of them play an important role in our health.
Written By:
Carmen Leitch
SEP 15, 2018
Clinical & Molecular DX
Anoikis have always been intimately entwined with cancer, henceforth the quest to seek how they came to be as such.
Written By:
Sharvin Manickam
SEP 01, 2018
Cancer
We have always been told to eat more vegetables as they are rich in many nutrients and vitamins as well as the ability t
...
Written By:
Heba El-wassef